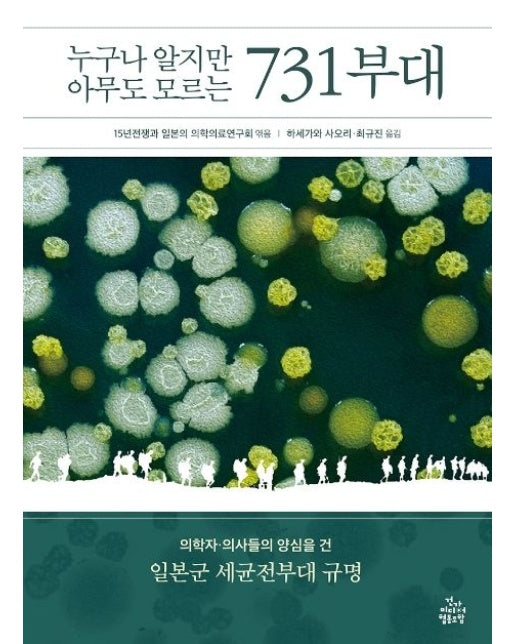
누구나 알지만 아무도 모르는 731부대 (의학자 의사들의 양심을 건 일본군 세균전부대 규명)

Description
누구나 알지만 아무도 모르는 731부대(원제: NO MORE 731)
- 가짜 생체해부 사진, 과장·왜곡된 731부대 얘기들은 이제 그만!
- 731부대와 제국주의에 대해 제대로 알고 싶은 분들에게 도움이 될 것입니다.
- 731부대는 결코 과거사가 아닙니다. 또한 일본만의 얘기도 아닙니다. 식민지와 전쟁의 아픔을 겪고 제국주의 열강 속에서 살고 있는 오늘날의 우리에게도 중요한 문제입니다.
- 특히 전쟁사, 의학사, 의료윤리에 관심 있는 연구자라면 읽어보시길 권합니다.
- 가짜 생체해부 사진, 과장·왜곡된 731부대 얘기들은 이제 그만!
- 731부대와 제국주의에 대해 제대로 알고 싶은 분들에게 도움이 될 것입니다.
- 731부대는 결코 과거사가 아닙니다. 또한 일본만의 얘기도 아닙니다. 식민지와 전쟁의 아픔을 겪고 제국주의 열강 속에서 살고 있는 오늘날의 우리에게도 중요한 문제입니다.
- 특히 전쟁사, 의학사, 의료윤리에 관심 있는 연구자라면 읽어보시길 권합니다.
누구나 알지만 아무도 모르는 731부대 (의학자 의사들의 양심을 건 일본군 세균전부대 규명)
$22.12